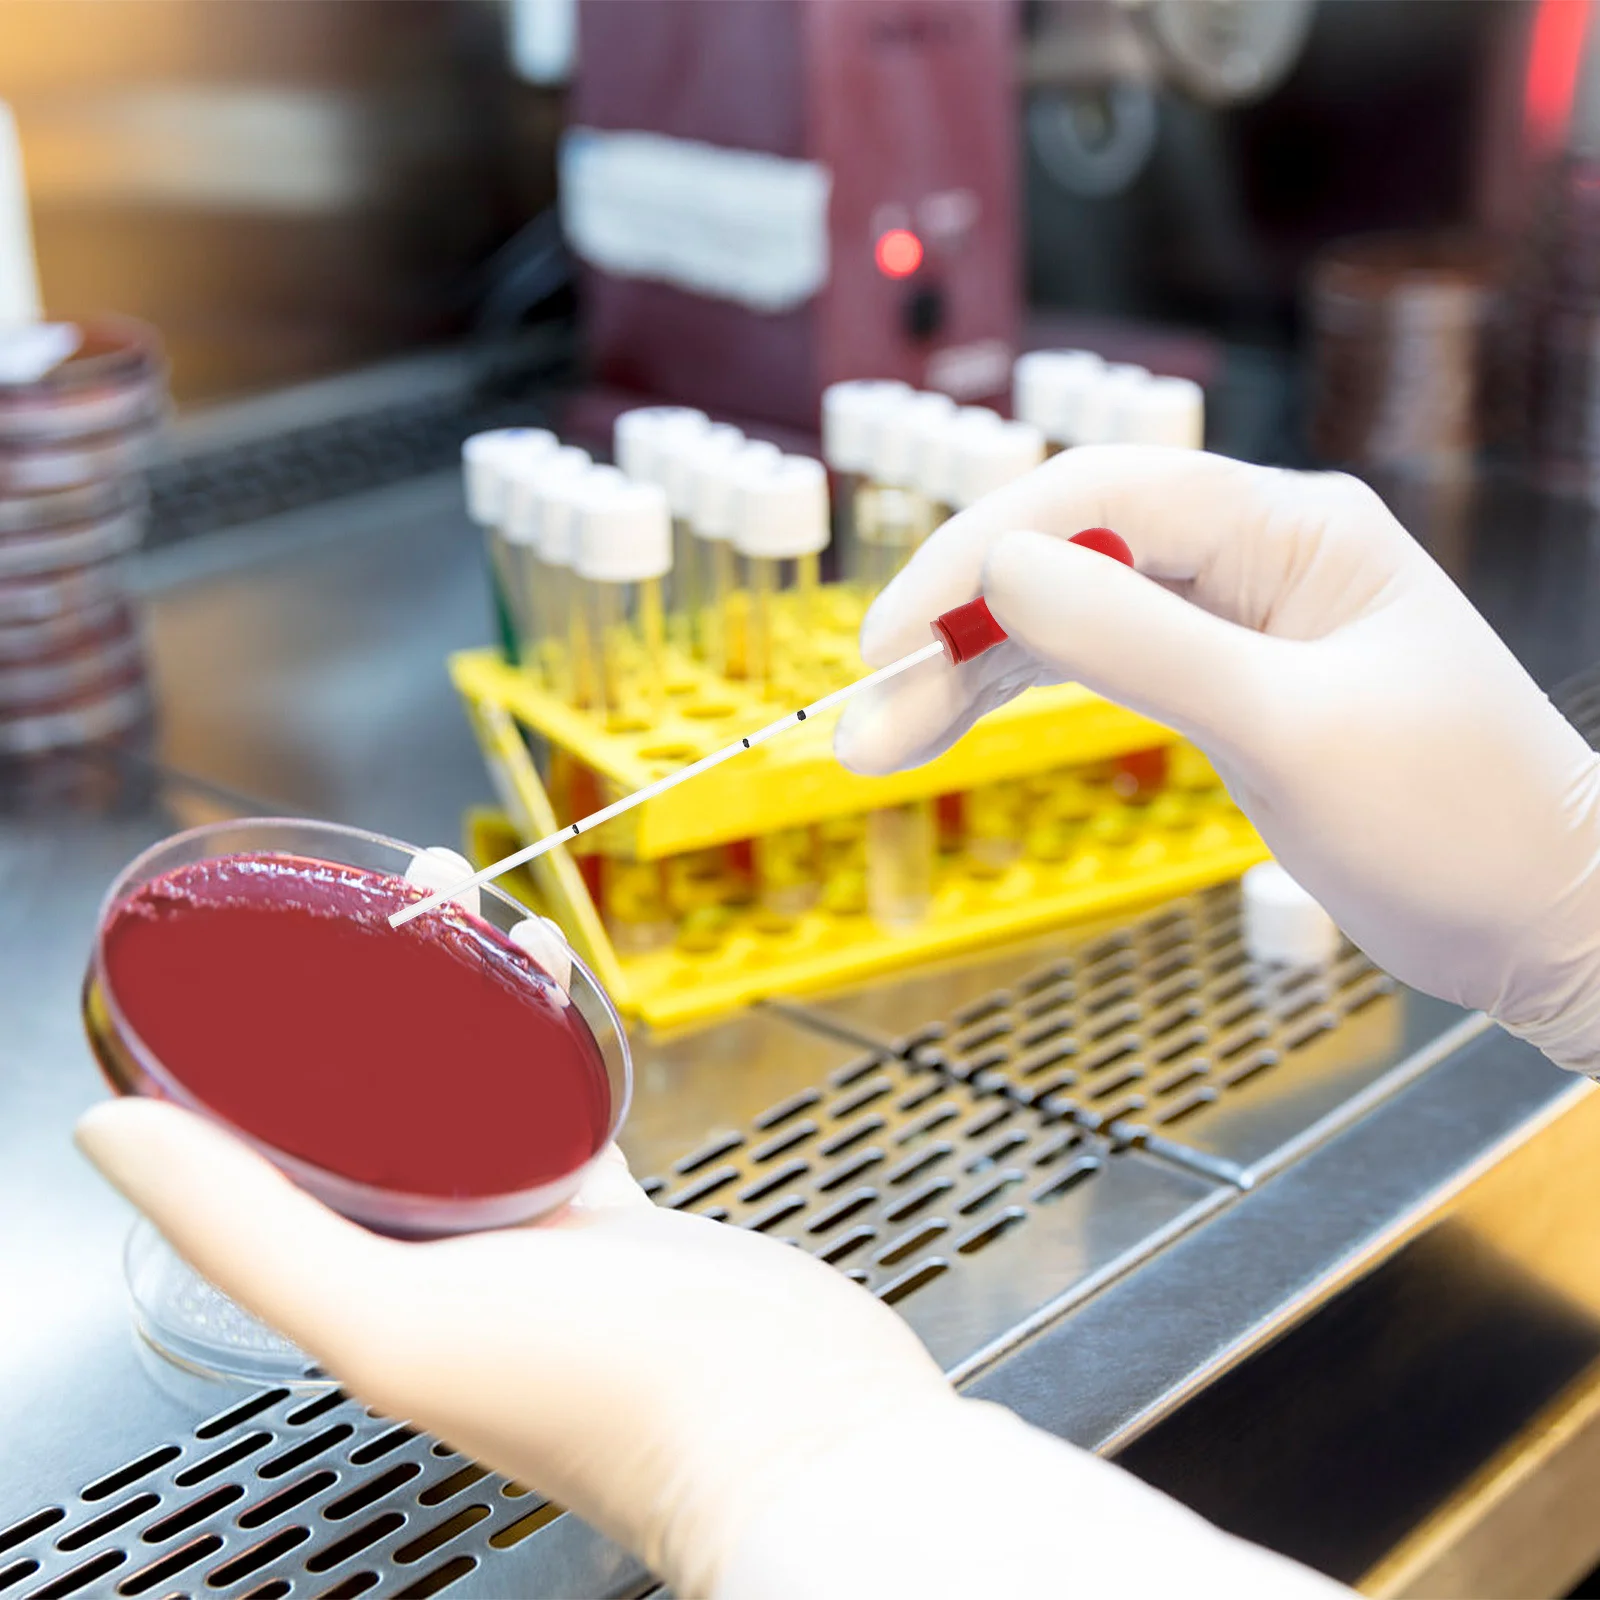
1Set Glass Blood Collection Tube Disposable Straw Suction Head for Blood Sample Collection Sampling

Передняя левая и правая Автомобильная фара, передняя фара головного света, лампа, объектив, лампа, чехол для Bmw F30 F31, 3 серии 2013-2016, 1 пара
Price history chart & currency exchange rate
Customers also viewed

$28.09
Universal modified Motorcycle Side Mirrors ALL-CNC Aluminum Alloy rearview Mirrors For Honda MSX Yamaha Kawasaki Suzuki Ducati
aliexpress.com
$2,684.54
980Nm 1470Nm Diode Laser Lipolisi Commercial Machine Physiotherapy Treatment Optic Fiber Liposuction Handle Fat Dissolving
aliexpress.com
$6.30
Hooks Adhesive Hook Wall Towel Self Shower Towels Bathroom Hat Hanging Hangers Inside Bathrooms Sticky Steel Stainless Rack
aliexpress.ru
$115.92
with box womens mens designer casual shoe track led sneaker light grey blue gomma leather black pink trainer nylon printed platform for men
dhgate.com
$3.89
BAMBOO Friendship Background Greeting Card Decoration Metal Cutting Dies DIY Stencil Scrapbooking Emboss Making 2021
aliexpress.com
$2.14
Silicone Ice Cube with Cover Lip Square DIY Soap Jelly Mold Chocolates Ice Cream Mould for Chilling Whiskey Cocktails Ice Water
aliexpress.com
$58.00
2021 New Summer Sandals Women 6 Cm High Heels PVC Chemical Fiber Material Rhinestones Decorated with Gorgeous Crystal Shoes33-40
aliexpress.com
$21.68
8inch 8-layer maple blank double concave skateboards natural skate deck board skateboards deck wood maple longboard
dhgate.com
$28.62
new arrival nails15ml gelpolish gelcolor uv led nail gel polish gel varnish coat base coat nail primer soak off lacquer, Red;pink
dhgate.com
$41.32
Холодильник для хранения, дренаж, двухслойная коробка для хранения, переносная коробка для фруктов, ящик для хранения на открытом воздухе белый
joom.ru
$0.54
New Summer simple Cute Ice Cream Long Earrings for women korean Resin Lovely Girls dangle earring 2020 statement fashion Jewelry
alibaba.com
$20.00
Original High Quality Yeezy Running Sports Shoes Men sneakers Fashion Yeezy 700 V3 Azareth Sneakers for Men, Sapphire gray green terracotta warriors
alibaba.com
$8.20
fashion 15 inch school cartoon bags special colorful fabric design kids bag with pencil case, 16 colors
alibaba.com
$11.11
DIY Tray Crystal Epoxy Resin Mold Nordic Human Body Abstract Line Dish Silicone Mold
aliexpress.com
$6.34
christmas decorations angel plush pendant elk decor for home tree ornaments xmas gifts1
dhgate.com
$118.83
Ракетка для большого тенниса Wilson Blade 98 18x20, Черный, Ракетка для большого тенниса Wilson Blade 98 18x20
sportmaster.ru
$1.70
Kpop Idol Bangtan Boys Key Ring Butter with Hairball Plastic Acrylic Keychain Key Chain Accessories Cute Key Pendant Wholesale
aliexpress.com
$15.02
Уличные колеса для роликовых коньков, 8 шт., 32X58 мм, четырехколесные роликовые коньки с подшипниками для двухрядного конька/скейтборда
aliexpress.com
$18.62
Переход из детского сада для начальной школы, с фокусом на языке и подготовкой по математике для прокрутки первого класса
aliexpress.ru
$4.80
HERLOOK Y2K Keychain with Star Bowknot Phone Chain Pendant Pearl Beads Cute Bag Charm Accessories Gift for Women Girls
aliexpress.ru
$23.58
Oil Painting Van Gogh Star Sky Bedding Set Boys Girls Twin Queen Size Duvet Cover Pillowcase Bed Kids Adult Home Textileextile
aliexpress.ru
$2.25
1Set Glass Blood Collection Tube Disposable Straw Suction Head for Blood Sample Collection Sampling
aliexpress.ru


















